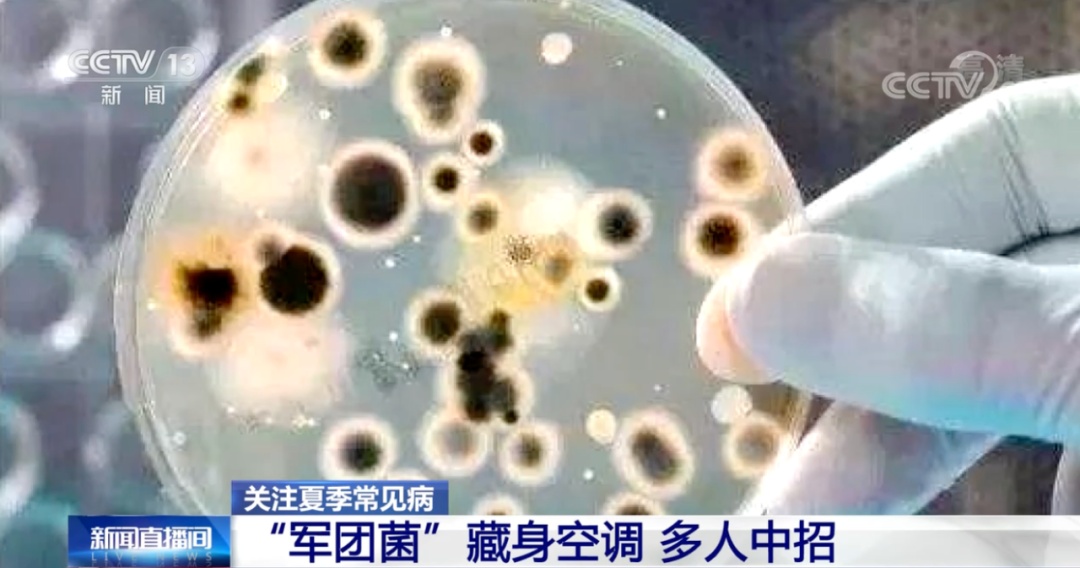
“军团菌”藏身空调,多人中招!紧急提醒→ “军团菌”藏身空调,多人中招!紧急提醒→

夏至一到,盛夏来临
空调成为很多人的“解暑神器”
但你知道吗?
长期未使用的空调
如果未经清洗就直接使用
可能存在健康隐患↓↓
两人因未洗空调感染军团菌肺炎
近日,长沙市中心医院
接连收治了两名军团菌肺炎患者
起病原因都与吹空调有关
据介绍
55岁的长沙市民周先生(化名)
近日因持续发热、寒战、咳嗽4天
在医院就诊后住院接受治疗
询问病史得知
患者入院前启动了久未清洗的车载空调
每天在车上的时间超过10小时
不久后,就出现了发热、咳嗽等
类似“感冒”的症状
经诊断,患者感染了军团菌肺炎
△周先生治疗前后的肺部CT影像
与周先生同一时间入院的
还有32岁的姚女士(化名)
据她介绍
家中的空调已有半年多未曾清洗
入院前她在家使用了两天空调
一周后相继出现了
咳嗽、咳痰、高热、寒战
以及呕吐、腹泻等症状
最终被确诊为重症军团菌肺炎
严重可致命!
军团菌肺炎是什么?
军团菌肺炎
是由军团菌引起的
以肺炎为主要表现的全身性疾病
症状:
军团菌肺炎侵入人体大约10天后发病,临床症状包括发热、咳嗽、咳痰、呼吸困难等非特异性呼吸道症状,以及头痛、肌痛、腹泻、恶心、呕吐、横纹肌溶解、急性肾功能损害等多种肺外表现,严重者可导致休克甚至死亡。
易感人群:
中老年人,慢性心、肺、肾病等基础疾病患者,爱吸烟者及孕妇等。
吹空调为何会感染军团菌?
军团菌偏好温暖潮湿的环境
而夏季炎热潮湿
是它繁殖的绝佳时机
空调若不经常使用、清洗
其散热片及冷却水系统中
会积聚大量军团菌
当空调送风时
军团菌以气溶胶的形式散布到空气中
被免疫力低下的人体吸入
随后发病
因此,每年6~9月
是军团菌肺炎的高发期
怎样预防军团菌?
预防军团菌侵袭
建议定期清洗空调↓↓
①外观擦洗
空调长时间不挪动,顶部及出风口往往灰尘很多,用拧过的湿抹布将出风口、外壁等认真擦洗一遍,等干燥后就能正常使用。
②过滤网刷洗
一般来说,打开空调外壳,即可拆下过滤网。用较为柔软的刷子仔细刷洗过滤网,可以在水中添加一些消毒剂,去除表面细菌,晾干后再装回去,全程无需专业人员就能操作。
③喷洒空调清洁剂
市面上有各种各样的空调清洁剂,都有一定的杀菌清洁作用,不过操作方式各异,具体要按照使用说明书进行。由于部分清洁剂可能会渗入空调内部,导致短路等隐患,安全起见,使用前一定要及时关闭空调电源。
避免“空调病”牢记这几点
除了军团菌
使用空调不当也容易引发
这些“空调病”↓↓
01
中暑
你知道吗?吹空调也可能中暑!
中医理念中
阳暑是高温导致中暑后大量出汗
阴暑则是发热但没有汗
如果使用空调不当
或吃了太多寒凉食物
出现头晕、恶心、腹痛、肠胃不适等症状
就说明中暑了
此时,可以口服或外涂十滴水
口服每次用量10滴左右
儿童和体弱的老人减量,一次5滴
因含有乙醇成分
孕妇和驾驶员不建议使用
外用时避免接触眼睛
02
湿气重
夏天天气潮湿
长时间待在空调房里
湿气容易侵袭人体
舌苔黄腻、舌头周边有齿痕
大便不成形、头发爱出油等
都是湿气重的表现
可服用薏苡仁和赤小豆来祛湿
03
膝盖不适
空调房里待久了
可能会感觉膝盖不舒服
可以试试这2个动作
帮您养护膝关节
动作一:膝关节屈曲
动作二:膝关节伸展
该如何正确使用空调?
这6点建议请牢记↓↓
①及时清洁空调
②避免骤冷骤热
③注意保湿
④温度不要过低
⑤适时通风
⑥避免直吹
享受凉爽的同时
切记正确使用空调哦~
综合《生活圈》、国家应急广播
来源: 央视一套